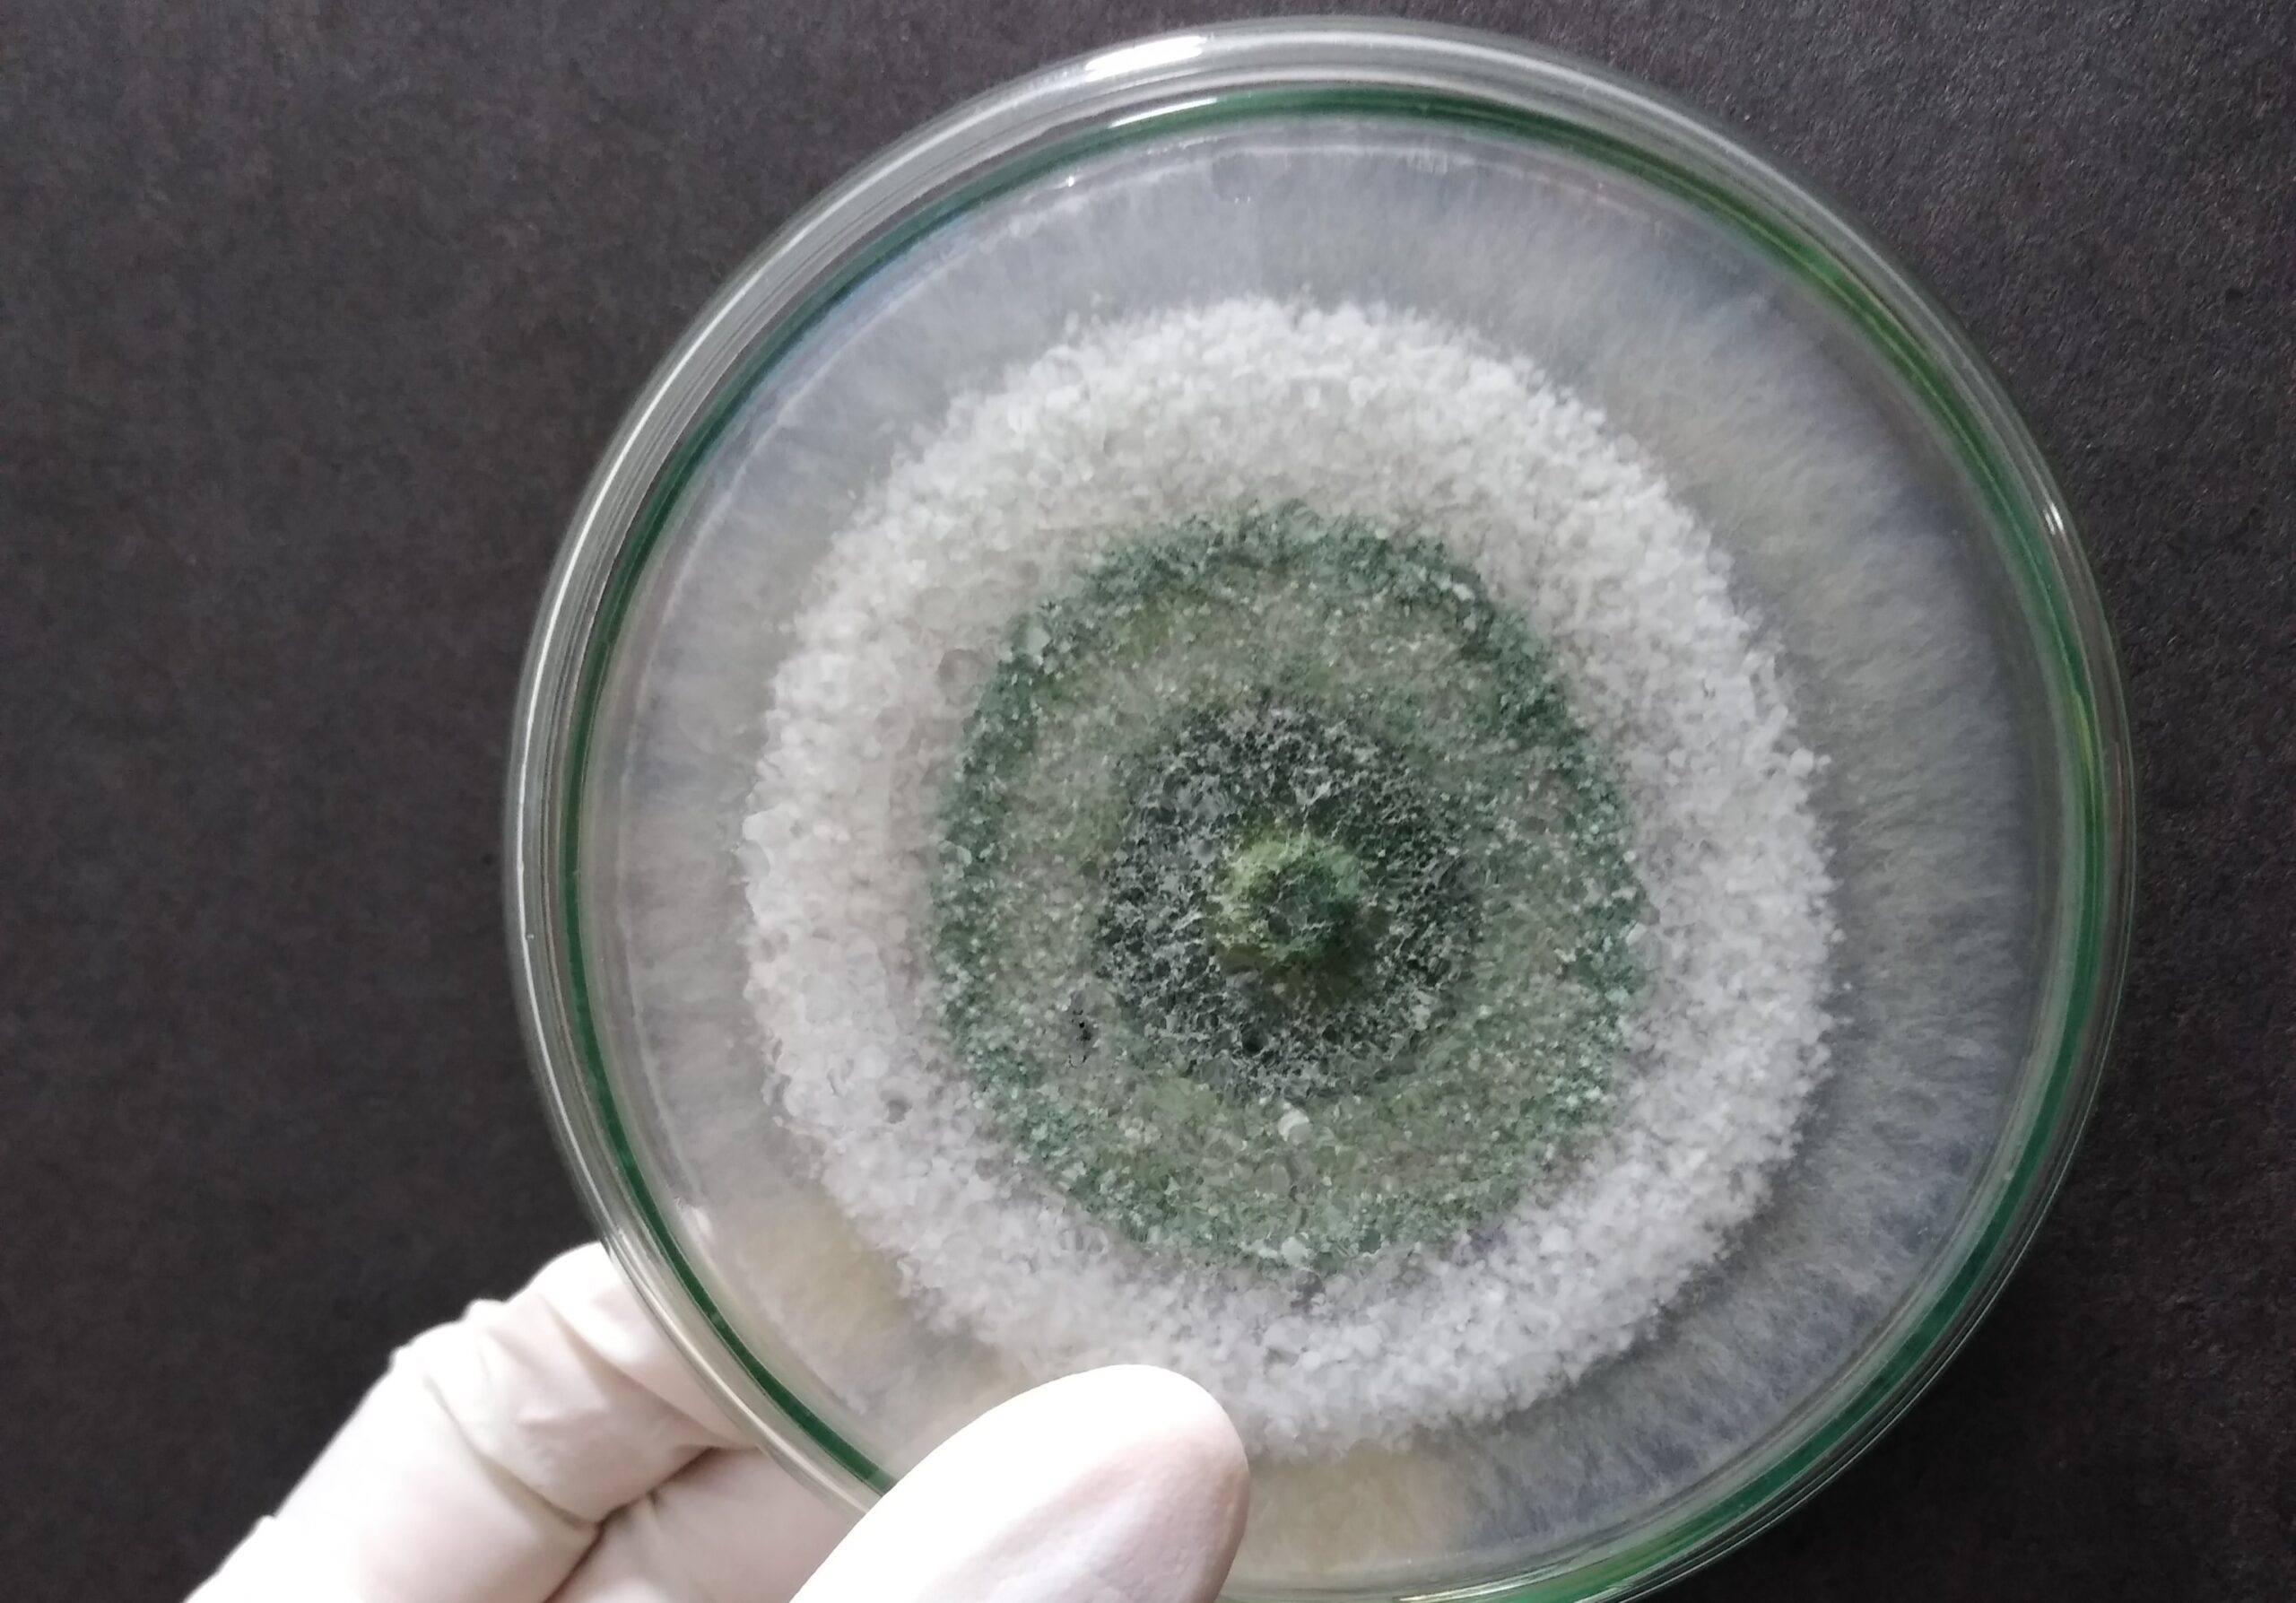

Alamorganik.com-Di era pertanian modern, petani semakin sadar pentingnya menjaga kesehatan tanaman secara alami. Salah satu solusi paling efektif adalah memanfaatkan agen hayati, dan salah satu yang paling populer adalah Trichoderma. Mikroba ini memiliki kemampuan unik untuk menghambat patogen tanaman sekaligus menyuburkan tanah, sehingga menjadi sahabat petani dalam menciptakan pertanian yang sehat dan produktif.
Apa Itu Trichoderma?
Trichoderma adalah jamur yang hidup di tanah dan dikenal sebagai agen hayati multifungsi. Jamur ini bekerja dengan mengontrol pertumbuhan jamur patogen yang menyerang akar, batang, atau daun tanaman. Selain itu, Trichoderma juga membantu meningkatkan kesuburan tanah dengan menguraikan bahan organik sehingga tanaman lebih mudah menyerap nutrisinya.
Mikroba ini sangat aman digunakan karena alami, ramah lingkungan, dan tidak menimbulkan residu kimia seperti pestisida. Karena keunggulannya, Trichoderma kini menjadi salah satu pilihan utama petani organik maupun konvensional.
Manfaat Trichoderma untuk Pertanian
Menggunakan Trichoderma memberikan banyak keuntungan, baik untuk tanaman maupun tanah:
- Menghambat Patogen Tanaman
Trichoderma mampu memproduksi enzim dan metabolit yang menekan pertumbuhan jamur atau bakteri penyebab penyakit. Contohnya, jamur patogen seperti Fusarium, Rhizoctonia, dan Pythium bisa dikendalikan sehingga tanaman lebih sehat. - Meningkatkan Pertumbuhan Tanaman
Trichoderma merangsang pertumbuhan akar dan meningkatkan kemampuan tanaman dalam menyerap nutrisi. Hasilnya, tanaman tumbuh lebih subur dan menghasilkan panen lebih optimal. - Menyuburkan Tanah
Sebagai pengurai alami, Trichoderma membantu menguraikan sisa tanaman dan bahan organik menjadi nutrisi yang siap diserap oleh akar. Tanah menjadi lebih gembur, kaya mikroba, dan lebih sehat untuk tanaman jangka panjang. - Meningkatkan Daya Tahan Tanaman
Tanaman yang ditanami Trichoderma cenderung lebih tahan terhadap stres lingkungan, seperti kekeringan, tanah kurang subur, atau serangan hama.
Cara Mengembangbiakkan Trichoderma

Mengembangbiakkan Trichoderma sebenarnya sangat mudah dan bisa dilakukan di rumah atau skala pertanian. Berikut langkah-langkah praktisnya:
1. Persiapan Bahan dan Media
Anda memerlukan bahan dasar berikut:
- Serbuk gergaji, bekatul, atau dedak padi sebagai media tumbuh.
- Air bersih untuk menjaga kelembaban media.
- Trichoderma starter (bisa diperoleh dari toko pertanian atau laboratorium mikrobiologi).
- Wadah bersih (kantong plastik, toples, atau ember steril).
2. Sterilisasi Media
Sterilisasi media penting untuk mencegah kontaminasi jamur atau bakteri lain:
- Panaskan media (serbuk gergaji atau bekatul) dengan air panas atau uap hingga bersih.
- Tiriskan dan biarkan dingin sebelum digunakan.
3. Inokulasi Trichoderma
- Ambil starter Trichoderma secukupnya.
- Campurkan media yang sudah Anda sterilkan secara merata.
- Pastikan media cukup lembab tapi tidak basah agar Trichoderma bisa tumbuh optimal.
4. Inkubasi
- Letakkan media yang sudah Anda inokulasi di tempat hangat (25–30°C).
- Tutup wadah dengan kain atau penutup yang memungkinkan udara masuk tapi melindungi dari debu.
- Biarkan selama 7–14 hari hingga media tertutup miselium putih Trichoderma.
5. Panen dan Penyimpanan
- Setelah jamur tumbuh merata dan berwarna putih kehijauan, petani bisa langsung menggunakan Trichoderma.
- Simpan di tempat kering dan sejuk, atau keringkan untuk dijadikan bahan inokulum jangka panjang.
Cara Menggunakan Trichoderma di Pertanian
Petani dapat mengaplikasikan Trichoderma melalui beberapa metode praktis:
- Pencampuran dengan Tanah
Campurkan Trichoderma ke dalam tanah sebelum menanam. Mikroba akan hidup di sekitar akar dan melindungi tanaman dari patogen. - Perendaman Bibit
Rendam bibit tanaman dalam suspensi Trichoderma sebelum petani menanamnya. Cara ini membantu akar menempel dengan cepat dan meningkatkan ketahanan awal terhadap penyakit. - Taburan di Permukaan Tanah
Taburkan Trichoderma di sekitar tanaman secara rutin untuk menjaga populasi mikroba aktif di tanah. - Pencampuran dengan Pupuk Organik
Petani bisa mencampurkan Trichoderma ke dalam kompos atau pupuk kandang untuk mempercepat penguraian bahan organik dan meningkatkan kesuburan tanah.
Tips Sukses Menggunakan Trichoderma
Agar Trichoderma bekerja maksimal, perhatikan beberapa hal berikut:
- Gunakan starter Trichoderma berkualitas dari sumber terpercaya.
- Jangan mencampur Trichoderma dengan pestisida kimia karena bisa membunuh mikroba.
- Jaga kelembaban tanah agar Trichoderma tetap aktif.
- Terapkan secara rutin, minimal 2–3 kali selama musim tanam.
- Simpan Trichoderma di tempat sejuk dan kering untuk menjaga viabilitasnya.
Studi Kasus Penggunaan Trichoderma

Banyak petani di Indonesia telah membuktikan efektivitas Trichoderma:
- Petani cabai di Jawa Tengah melaporkan penurunan penyakit akar hingga 60% setelah rutin menggunakan Trichoderma.
- Petani padi organik di Bali mencampurkan Trichoderma ke dalam tanah sebelum menanam, sehingga mereka berhasil meningkatkan hasil panen 15–20%.
- Petani sayuran hidroponik menggunakan Trichoderma untuk menjaga akar tetap sehat dan mencegah jamur patogen yang sering muncul di sistem air.
Mengembangbiakkan Trichoderma bukan sekadar tren pertanian organik, tetapi strategi cerdas untuk pertanian berkelanjutan. Jamur ini berperan ganda: menghambat patogen yang merusak tanaman dan menyuburkan tanah agar tanaman tumbuh lebih sehat dan produktif.
Dengan teknik yang tepat, penggunaan Trichoderma dapat mengurangi ketergantungan pada pestisida dan pupuk kimia, menekan biaya produksi, serta mendukung pertanian yang ramah lingkungan.
Petani yang ingin tanaman lebih sehat, tanah lebih subur, dan hasil panen maksimal harus mempertimbangkan Trichoderma sebagai sahabat alami di lahan mereka. (rull)









